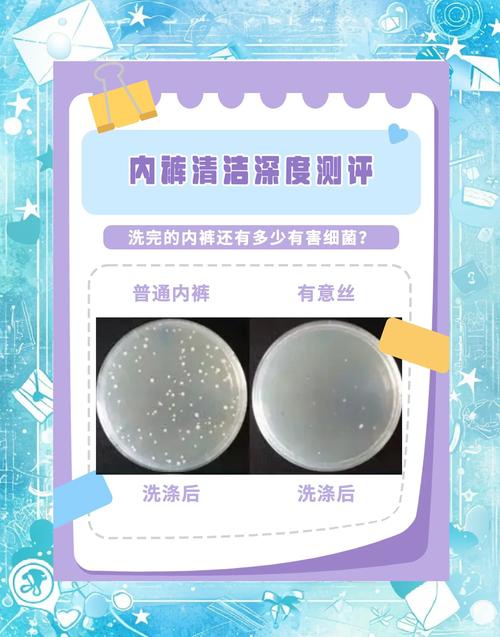

其实内裤用火烤了一下会杀菌吗的问题并不复杂,但是又很多的朋友都不太了解内裤用火烤干能穿吗?,因此呢,今天小编就来为大家分享内裤用火烤了一下会杀菌吗的一些知识,希望可以帮助到大家,下面我们一起来看看这个问题的分析吧!
内裤在炉子旁烤干能杀死细菌吗?
在炉子旁放一盆冷水并不能防止煤气中毒。水分在高温下与煤发生化学反应,生成一种名为水煤气的混合气体,其中含有大量一氧化碳。由于水煤气比重大,更容易在室内积聚,从而增加了中毒的风险。
丁烷气罐有一定危险性,应正确操作使用,远离热源。丁烷气瓶上的“注意事项”中标明,便携式丁烷气瓶属于高度易燃物品。而这种气瓶使用也有严格规范,如点火前检查接口是否漏气,严禁将罐体倾斜、倒置等。有丁烷气罐的便携式加热炉,很多人都不陌生,因为使用方便,许多烧烤店、火锅店经常能见到它的身影。
吊兰,还能排放出杀菌素,杀死病菌,若房间里放有足够的吊兰,24小时之内,80%的有害物质会被杀死;吊兰还可以有效地吸收二氧化碳。 紫苑属、黄耆、含烟草和鸡冠花,这类植物能吸收大量的铀等放射性核素。 常青藤、月季、蔷薇、芦荟和万年青,可有效清除室内的三氯乙烯、硫比氢、苯、苯酚、氟化氢和乙醚等。
樟脑球放衣柜里可以(在你不讨厌樟脑味的情况下),可是放食品柜里怕不行。下面这些都是很好找的简单方法:保持衣物洁净。蛀虫、衣蛾、蟑螂等都怕光,所以经常穿的衣服以及时常会用的羊毛毯子一般是不会滋生害虫的。定期通风,检查衣柜内是否潮湿。
有种内裤遇热图案消失,冷又出现,说是杀菌,有科学依据吗
有人声称这种内裤能杀菌,但我对此表示怀疑。我觉得这种说法并没有充分的科学依据。
不安全。内裤上的色素大多含有染料,染料中含有的化学物质在高温下会加速分解,而且温度越高,染料分解的越快,内裤上的图案消失的也就越快,然而内裤在高温热水中烫洗时,上面的色素容易掉落,会被人体吸收,从而对人体健康造成影响,所以内裤遇热图案消失不安全。
这种叫做热敏变色印花,随着温度变化,使纺织品上面的花纹颜色发生改变,产生独特的动态变化的效果,也可称纺织品隐影印花,就是使纺织品上的花纹图案的色泽随着周围环境温度的变化、织物干湿的变化等等,而引起花纹图案的色泽也随之忽隐忽现的变化功能。

内裤用小太阳烤干算消毒吗
〖One〗、可以经常用滚开水浸泡和清洗内裤的,既起到消毒的作用,又祛除了没条件暴晒而所留在内裤上的细菌。既简单又安全卫生。
〖Two〗、很多人会选取用吹风机,虽然这个方法可以是可以就是见效很慢,还会占用你很长时间,所以家里有小太阳的直接用小太阳烤干。此外,就是在阴雨天的时候,女性换内裤一定要当天就清洗,等到第二天内裤没有水分了,再开始烘干内裤。
〖Three〗、通讯设备:对讲机20个,卫星电话2个,用于远距离通讯。电源设备:线长8米插排100个,太阳能热水器、净水器各2套(备用),太阳能电池板200平方米(铺满房顶及可见光处),大功率静音发电机3台,蓄电池、变压器、稳定器各10套,确保电力和用水安全。

妈妈把内裤放到烤火炉上烤了,但是我有点洁癖,把我的内裤放到别人烤...
用你认为可以清洗干净的方法洗一遍,除了丢掉。不会的。火能消毒,无论什么毒都能消。不知道你知道不:在古代没有消毒药水和酒精的时候,医生给病人开刀、针灸和手术的时候都是用火烧烧银针或手术刀的。
母亲心是纯洁的,至高无上的每一个母亲,都有一果肉最虔诚的爱心。隐藏着一种真挚的爱。我的妈妈长着一双炯炯有神的眼睛,一头乌黑的头发中夹杂着几根银发,那也许是她劳累一生的见证。别的妈妈对自己的子女都很关心,我的妈妈也不例外。
唉,老师又布置写妈妈的作文了,写些什么呢?我的妈妈在人们眼中是个能干的人,热爱劳动,厨艺也不错;可是在我眼中却是个十足的小孩。她一不对劲,就和我闹“矛盾”,要么不理我,要么总是和我唱反调,对着干,这事儿令我非常伤脑筋。伤脑筋之一:妈妈是个话篓子。
仿写段)仍然是用她那廉价的洗洁精,母亲先把手中倒上一些,到用来擦拭碗的布上擦了些水,再以清水浇洗碗,又去水池中浸泡。说时迟,那时快,手中的洗洁精已经不见了,正在碗的内心。 (仿写段)渐渐地母亲的动作慢了下来,白色的釉质也都摞在了一边。
可小女孩懂得了,在她看了那部电视以后,她懂得了一切,自己的无理取闹是没有用的,自己的自卑是没有用的。因为没有了妈妈不需太悲,没有了妈妈并不代表自己的生命失去了色彩,失去了前有的光茫 当她懂得这一切时。那年,她12岁。她换了个环境,换了个学校。

冬天没有太阳怎么晒内裤
对于没有晒太阳条件的人来说,洗净的内裤应置于通风处晾干。虽然晒不到阳光,但良好的通风同样重要。 洗净的内裤建议在阳光下晾晒,紫外线能够有效杀菌,有助于保持内裤的卫生。 避免在既无阳光又无通风的环境中晾干内裤,这样做容易导致细菌滋生。 洗后的内裤可以使用84消毒液等进行浸泡,以达到初步杀菌消毒的效果。
内裤若无法在阳光下晾晒,可以采用熨斗烫平、烘干机烘干或吹风机吹至干燥的方法。直接暴露在太阳下晾晒内裤可能会导致其变形和变硬,因此建议先在阴凉处将内裤吹干一部分,再移至阳光下进行最后的晒干。如果没有阳光,熨斗、烘干机和吹风机是可行的替代方案。
部分人没有晒太阳的条件,内裤洗净后应该放在通风处晾干,晒不到太阳可以通风。内裤洗完后推荐在太阳光下暴晒,可以起到灭菌的作用,因为太阳光中含有的紫外线杀菌能力较强。不能在既没有阳光,又没有通风的环境中晾干内裤,会聚集很多细菌。
关于内裤用火烤了一下会杀菌吗和内裤用火烤干能穿吗?的介绍到此就结束了,不知道你从中找到你需要的信息了吗 ?如果你还想了解更多这方面的信息,记得收藏关注本站。

发表评论
评论列表